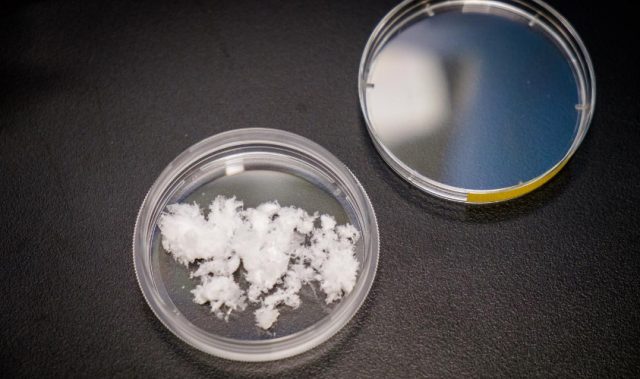

AsianScientist (Jan. 3, 2018) – In a study published in the journal Small Methods, scientists in Singapore have developed a skin patch that reduces weight gain in mice.
Obesity, which results from an excessive accumulation of fat, is a major health risk factor for various diseases, including heart disease, stroke and type-2 diabetes. The World Health Organization estimates that 1.9 billion adults in the world were overweight in 2016, with 650 million of them being classified as severely obese. Clinical interventions to reduce fat accumulation and prevent obesity are thus needed.
In this study, a research group led by Professor Chen Peng and Assistant Professor Xu Chenjie at the Nanyang Technological University (NTU), Singapore, have created a skin patch containing hundreds of micro-needles, each thinner than a human hair, which are loaded with the drug beta-3 adrenergic receptor agonist or another drug called thyroid hormone T3 triiodothyronine.
The beta-3 adrenergic receptor agonist is a drug approved by the Federal Drug Administration of the United States and is used to treat overactive bladders, while T3 triiodothyronine is a thyroid hormone commonly used as medication for an underactive thyroid gland. Both have been shown in other research studies to be able to turn white fats into a fat-burning counterpart known as brown fat. However, their use in weight control is hampered by potentially serious side-effects from drug accumulation in non-targeted tissues.
When included in the micro-needles, the drugs’ dosage can be reduced and they can be more directly targeted into the fat beneath the skin.
“The amount of drugs we used in the patch is much less than those used in oral medication or an injected dose. This lowers the drug ingredient costs while our slow-release design minimizes its side effects,” said Xu of NTU.
“With the embedded microneedles in the skin of the mice, the surrounding fats started browning in five days, which helped to increase the energy expenditure of the mice, leading to a reduction in body fat gain,” Xu added.
The researchers demonstrated that the patch could suppress weight gain in mice that were fed a high fat diet, as well as reduce the fat mass of these mice by over 30 per cent, over a period of four weeks. The mice receiving treatment also had significantly lower blood cholesterol and fatty acids levels compared to the untreated mice.
“What we aim to develop is a painless patch that everyone could use easily, is unobtrusive and yet affordable,” said Chen of NTU. “Most importantly, our solution aims to use a person’s own body fats to burn more energy, which is a natural process in babies which have brown fat.”
NTU’s Lee Kong Chian School of Medicine Associate Professor Melvin Leow, who was not affiliated with this study, said it was exciting to be able to tackle obesity via the browning of white fat, also noting that the results of the study were promising.
“These data should encourage Phase I Clinical studies in humans to translate these basic science findings to the bedside, with the hope that these microneedle patches may be developed into an established cost-effective modality for the prevention or treatment of obesity in the near future,” said Leow.
The article can be found at: Than et al. (2017) Transdermal Delivery of Anti-Obesity Compounds to Subcutaneous Adipose Tissue with Polymeric Microneedle Patches.
———
Source: Nanyang Technological University.
Disclaimer: This article does not necessarily reflect the views of AsianScientist or its staff.